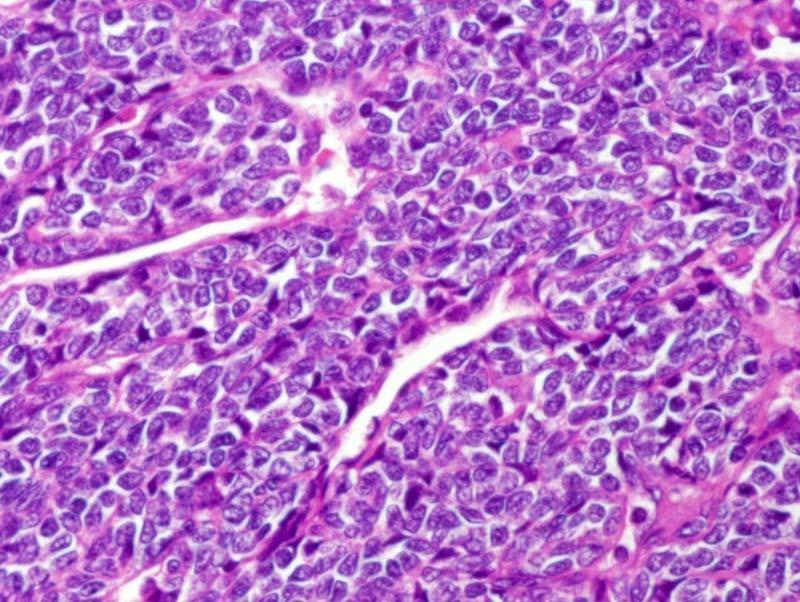
Charlie Herndon tweet media
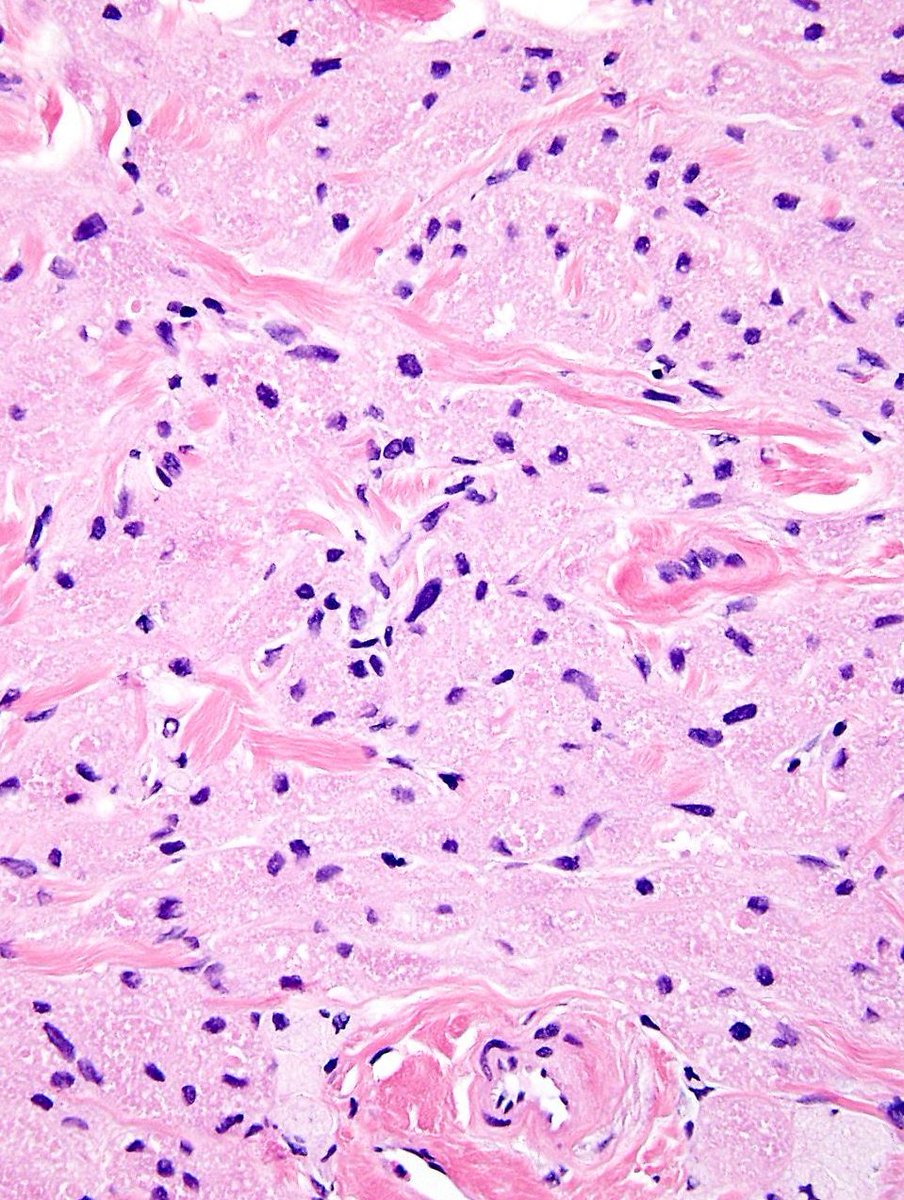
Charlie Herndon tweet media

Sabitlenmiş Tweet
Amanda Ireland
3.4K posts

Amanda Ireland
@AmandaIreland1
Anatomical pathologist and cytopathologist with special interest in Dermatopathology (RCPA post graduate diploma of Dermatopathology)
Perth, Western Australia Katılım Mayıs 2011
634 Takip Edilen991 Takipçiler
Amanda Ireland retweetledi

#PathQuiz 🔬 #Liver
Clue in caption 🧐
A) Hepatocellular carcinoma
B) Combined HCC-CCA
C) Intrahepatic cholangiocarcinoma
D) Intermediate cell carcinoma
#Pathology #GIPath @IARCWHO

Română
Amanda Ireland retweetledi

#PathQuiz 🔬
A) Endometrial polyp
B) Adenomyoma
C) Low-grade endometrioid carcinoma
D) Atypical polypoid adenomyoma
#Pathology #GYNPath @IARCWHO
Clue in caption 🧐

Català

@forthejon @HoustonArsenal I share many of the concerns she did. Prame not positive enough technically but dead negative intradermal component reassuring. Would have also sent for further testing.
English

Advanced #dermpath case alert! Eventually you'll run across a worrisome mole in a young patient that is not a Spitz. What do you do>. Here is how expert dermpath Dr. Hadas Skupsky worked it up.
kikoxp.com/posts/75416
#pathtwitter #dermtwitter
English
Amanda Ireland retweetledi

#GUPath #Surgpath #Pathtwitter #PathX
#Pathresidents: Let’s take a look at two biopsy cores (from the same patient) and decide what to call them.
Take a look at both cases (“A” in this post, “B” in reply). Cast your vote. Then, read on for some teaching points geared towards trainees and general fans of #GUPath.



English
Amanda Ireland retweetledi

#PathQuiz 🔬
45M presents with hypertension and a 40 mm gastric fundus mass.
A) Neuroendocrine tumor
B) Schwannoma
C) Ganglioneuroma
D) Paraganglioma
#Pathology #GIPath
Clue in caption 🧐

English
Amanda Ireland retweetledi

#PathQuiz 🔬
Which molecular alteration is expected?
A) MDM2 amplification
B) WWTR1::CAMTA1 fusion
C) SMARCB1 loss
D) YAP1::TFE3 fusion
#Pathology #SoftTissuePath #MolecularPath
Clue in caption 🧐

English
Amanda Ireland retweetledi

#PathQuiz 🔬
______ fusion
A) ASPSCR1::TFE3
B) WWTR1::CAMTA1
C) FUS::DDIT3
D) HEY1::NCOA2
#Pathology #SoftTissuePath #MolecularPath
Clue in caption 🧐

English
Amanda Ireland retweetledi

#PathQuiz 🔬
A) USP6 rearrangement
B) MYOD1 mutation
C) CTNNB1 mutation
D) GNAS mutation
#Pathology #SoftTissuePath #MolecularPath
Clue in caption 🧐


English
Amanda Ireland retweetledi

#PathQuiz 🔬
A) FUS::DDIT3 fusion
B) RB1 loss
C) PLAG1 rearrangement
D) MDM2 amplification
#Pathology #SoftTissuePath #MolecularPath
Clue in caption 🧐

English
Amanda Ireland retweetledi

#PathQuiz 🔬
___________ fusion
A) ETV6::NTRK3
B) FUS::CREB3L2
C) MYH9::USP6
D) COL1A1::PDGFB
#Pathology #SoftTissuePath #DermPath
Clue in caption 🧐

Français
Amanda Ireland retweetledi

#PathQuiz 🔬
__________ fusion
A) FUS::DDIT3
B) EWSR1::FLI1
C) COL1A1::PDGFB
D) SS18::SSX
#Pathology #SoftTissuePath #Sarcoma
Clue in caption 🧐


English
Amanda Ireland retweetledi

#PathQuiz 🔬
A) Dysgerminoma
B) Embryonal Carcinoma
C) Immature teratoma
D) Yolk sac tumor
#Pathology #GYNPath @IARCWHO

Română

@drkeithsiau Thank you. I am so sick of the name sebaceous cyst. Cysts with actual sebaceous differentiation (steatocystomas) do not present like this.
English
Amanda Ireland retweetledi

#TooFarToDiagnose?
#PathQuiz 🔬
A) Desmoid fibromatosis
B) Schwannoma
C) Synovial sarcoma
D) Calcifying fibrous tumor
#Pathology #GIPath
Clue in caption 🧐

English
Amanda Ireland retweetledi

#TooFarToDiagnose?
#PathQuiz 🔬
A) Fibroma
B) Sertoli cell tumor
C) Thecoma
D) Adult granulosa cell tumor
#Pathology #GYNPath

Italiano
Amanda Ireland retweetledi

#PathQuiz 🔬
What is your diagnosis?
A) Thecoma
B) Sertoli cell tumor
C) Sclerosing stromal tumor
D) Fibroma
#Pathology #GYNPath #OvarianTumor
Clue in caption 🧐

English
Amanda Ireland retweetledi

#PathQuiz 🔬
52-year-old female with an incidental 15 mm yellowish distal esophageal nodule.
A) Leiomyoma
B) Granular cell tumor
C) Schwannoma
D) Well differentiated SCC
#Pathology #GIPath
Clue in caption 🧐

English
Amanda Ireland retweetledi

#PathQuiz 🔬
A) Myxoid liposarcoma
B) Myxofibrosarcoma
C) Ossifying fibromyxoid tumor
D) Extraskeletal myxoid chondrosarcoma
#Pathology #SoftTissuePath #Sarcoma
Clue in caption 🧐

Amanda Ireland retweetledi

#PathQuiz 🔬 #Liver
A) Hepatocellular carcinoma
B) Gastrointestinal stromal tumor
C) PEComa (Angiomyolipoma)
D) Lipoma
#Pathology #GIPath
Clue in caption 🧐

Català
Amanda Ireland retweetledi

#PathQuiz 🔬🦴
A) Synovial sarcoma
B) Osteofibrous dysplasia
C) Ewing sarcoma
D) Adamantinoma
#Pathology #BonePath #Sarcoma
Clue in caption 🧐

Català




